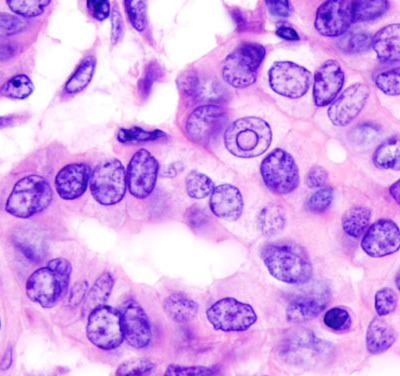

Врачи выделили три наиболее агрессивных вида рака
Врачи выделили три наиболее агрессивных вида рака, которые могут проявляться через общий симптом. Практика показывает, что определенные формы онкологии легче выявить на ранних стадиях. Например, рак кожи может быть обнаружен рано, если пациент обращает внимание на внешние проявления, такие как шишки на теле или изменения в родинках.
Среди особенно трудно обнаруживаемых видов рака выделяют рак поджелудочной железы, рак яичников и рак кишечника. Эти заболевания могут маскироваться под менее опасные состояния, такие как диабет или проблемы с пищеварением.
Все перечисленные формы онкологии часто сопровождаются симптомами, связанными с нарушением функции кишечника, такими как вздутие, запор или диарея. Врачи подчеркивают важность обращения внимания на эти признаки. Также отмечается, что потеря веса может быть одним из общих симптомов развивающейся онкологии у пациентов, сообщает Российская Газета.
Подписывайтесь на NewsInfo.Ru